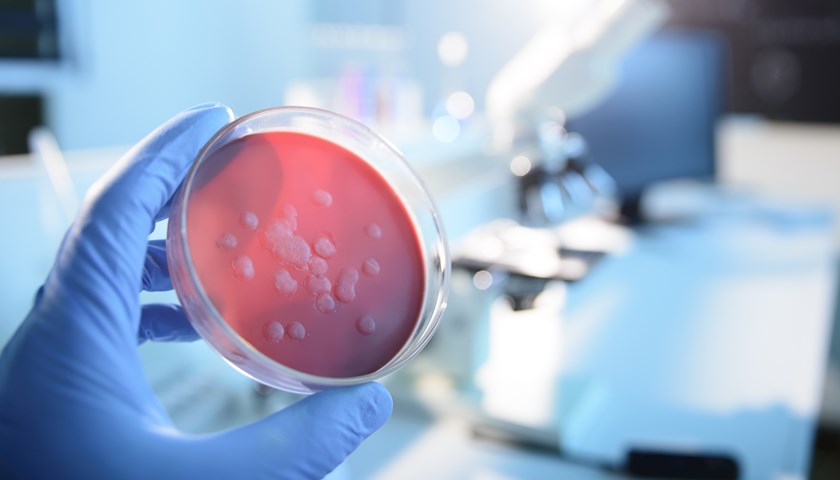

卫健委:7月份全国法定传染病疫情共死亡1930人
国家卫健委8月28日公布数据显示,7月,全国共报告法定传染病471455例,死亡1930人。其中,甲类传染病中鼠疫报告1例发病,霍乱报告3例发病,无死亡报告。乙类传染病中传染性非典型肺炎、脊髓灰质炎、人感染高致病性禽流感、白喉和人感染H7N9禽流感无发病、死亡报告,其余22种乙类传染病共报告发病300776例,报告死亡1927人。报告发病数居前5位的病种依次为病毒性肝炎、肺结核、梅毒、淋病以及细菌性和阿米巴性痢疾,占乙类传染病报告病例总数的95%。7月1日0时至7月31日24时,全国报告新型冠状病毒肺炎确诊病例803例,无死亡病例报告。
国家林草局:9月底前完成禁食野生动物后续工作
据国家林草局网站8月28日消息,国家林草局近日召开禁食野生动物后续工作视频调度会,督导各地推进禁食野生动物后续工作,要求9月底前全面完成禁食野生动物后续工作。据国家林草局调度,截至8月26日,共有25个省(区、市)出台了省级处置办法,19个省(区、市)制定了省级补偿方案。国家林草局将建立督导机制,对重点省份国家林草局各派出机构将重点督导,特别是对进展慢的省份将实行挂牌督导、专人蹲点,加快工作进度。
海关总署暂停澳大利亚1家牛肉企业对华出口
海关总署8月28日公布,8月26日,因输华牛腰脊肉中检出中澳两国禁用药物氯霉素,海关总署暂停澳大利亚牛肉生产企业JOHN DEE WARWICK PTY LTD(注册编号为243)对华出口。检出问题产品被销毁处理,未予入境。为保障进口肉类产品安全,海关已正式通报澳方,暂停该企业对华出口,要求澳方在45天内对相关企业进行全面调查并向中方反馈。有关暂停信息已在总署网站进出口食品安全信息服务栏目《符合评估要求的国家或地区输华肉类产品名单》中公布。
中央纪委国家监委:把制止餐饮浪费作为纠四风重要方面
据中央纪委国家监委网站8月28日消息,近日,中央纪委国家监委印发《关于贯彻落实习近平总书记重要批示精神 加强监督执纪坚决制止餐饮浪费行为的工作意见》,要求各级纪检监察机关把监督节约粮食、坚决制止餐饮浪费作为一项重要任务。各级纪检监察机关要紧盯各级领导机关、党员领导干部和公职人员等重点对象,把节约粮食、制止餐饮浪费作为落实中央八项规定精神、纠治“四风”的重要方面,纳入监督检查、巡视巡察的重要内容,强化日常监督。与此同时,要进一步拓宽监督渠道,充分利用“四风”问题举报平台,及时受理干部群众举报。
教育部:全国成人高考10月24日开考,严防冒名顶替
教育部8月28日在其官网发布《教育部办公厅关于做好2020年全国成人高校招生工作的通知》,通知明确,2020年全国成人高考安排在10月24日至25日进行。通知要求各地指导属地高校认真开展新生入学资格复查,对不符合报考条件或弄虚作假、违纪舞弊者,一律按有关规定取消其入学资格,并通报其所在地省级招生考试机构倒查追责。在考试组织方面,通知要求各地要严格疫情防控措施,做好考生和工作人员健康监测,制定完善防疫突发事件应急预案康。
扶贫办:1.3万户可能返贫,贫困地区名人带货要算经济账
国务院扶贫开发领导小组办公室副主任洪天云8月28日在国新办新闻发布会上说,入汛以来,部分省份洪灾严重,截至8月21日,安徽等9个省市出现严重洪涝灾害,涉及296个贫困县、15336个贫困村,受灾民众超过200万人。各级政府特别是扶贫部门采取有效措施,其中可能出现返贫的接近13000户,已及时纳入新的监测体系。洪天云还表示,贫困地区对直播带货的产品要算好经济账,目前少数地区请名人大牌,最后算账下来,请名人花的费用和直播带货以后的效应不成正比,成反比,花了好几十万、上百万,最后直播带货的销售才小几十万,所以这方面也是教训。
生态环境部:环评文件弄虚作假,发现一起严惩一起
8月28日上午,生态环境部召开例行新闻发布会,生态环境部环境影响评价与排放管理司司长刘志全在回答记者提问时表示,生态环境部门对环评文件弄虚作假、粗制滥造、不负责任始终坚持零容忍态度,发现一起、严惩一起、曝光一起。近期,生态环境部集中向浙江、江西、湖南、广东、广西、四川等六省(区)生态环境部门,移送了监管中发现的10项环评文件严重质量问题线索,要求依法开展调查取证,对存在的违法行为依法查处,涉嫌犯罪的,还将移送司法机关追究刑事责任。后续调查处理结果生态环境部和各地将及时向社会公开。
自然资源部:中国将现有红树林全部划入生态保护红线
自然资源部生态修复司司长周远波8月28日在新闻发布会上表示,将红树林以及红树林适宜恢复区域全部划入生态保护红线。在人类活动的影响下,全世界红树林的面积正以年均1%的速度减少,并面临着生物多样性降低、生态系统服务功能退化等严重威胁。近年来,我国加强红树林保护,2019年,我国红树林面积恢复至2.89万公顷,成为世界上少数红树林面积净增加的国家之一。但总体面积仍然偏小,仅占全球的0.2%。近日,自然资源部、国家林业和草原局联合印发《红树林保护修复专项行动计划》(2020-2025年)。对浙江省、福建省、广东省、广西壮族自治区、海南省现有红树林实施全面保护。
两部门联合启动现代产业学院建设,将建动态调整机制
据教育部网站8月28日消息,近日,教育部、工业和信息化部联合发布《现代产业学院建设指南(试行)》,提出建设若干高校与地方政府、行业企业等多主体共建共管共享的现代产业学院。两部门根据国家经济社会发展需求,指导和组织开展现代产业学院立项建设和评估。具备条件的高校按流程向教育部高等教育司提出申请,同时按规定向工业和信息化部人事教育司报备。教育部、工业和信息化部组织专家进行论证,按照“分区论证、试点先行、分批启动”的原则进行培育建设,并根据建设成效进行动态调整。
水利部:黄河流域“四乱”问题增量基本得到遏制
据央视新闻8月28日报道,记者从水利部了解到,目前黄河流域河湖管护责任体系基本形成,黄河流域乱占、乱采、乱堆、乱建等“四乱”问题增量基本得到遏制,河湖面貌明显改善。截至目前,沿黄9省区已设立省、市、县、乡四级河长湖长8.4万多名,打通了河湖管理保护的“最后一公里”。2019年,黄河流域9省(自治区)累计清理整治河湖“四乱”问题40577个。今年以来,又排查“四乱”问题6000多个,正在积极清理整治。



评论